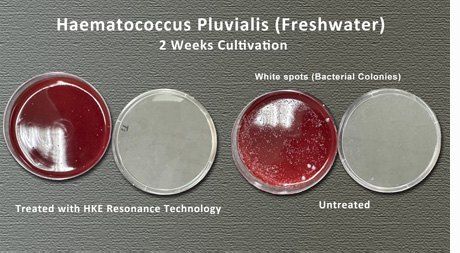

Research Background and Objective
 Spirulina (Spirulina) and Haematococcus pluvialis are high-value microalgae associated with two representative bioactive components—C-phycocyanin (C-PC) and astaxanthin, respectively.
In large-scale production, instability in cultivation water conditions—such as insufficient dissolved oxygen (DO), DO fluctuations, or pH deviation—often adversely affects algal growth, microbial ecology, and extraction efficiency.
Spirulina (Spirulina) and Haematococcus pluvialis are high-value microalgae associated with two representative bioactive components—C-phycocyanin (C-PC) and astaxanthin, respectively.
In large-scale production, instability in cultivation water conditions—such as insufficient dissolved oxygen (DO), DO fluctuations, or pH deviation—often adversely affects algal growth, microbial ecology, and extraction efficiency.
Experimental studies and observations conducted with the participation of Professor Su’s research team from the Department of Marine Biotechnology, National Kaohsiung University of Science and Technology, demonstrate the application value of HKE physical resonance technology – based water regulation in microalgae cultivation and extraction processes.
Overview of Research Methods
This integrated study covers three main aspects:
A. Cultivation Results: Water Quality Advantages Derived from DO and pH Stability
A1|Freshwater Haematococcus pluvialis: Plate Cultivation Reveals Differences in Microbial Profiles
 The results show that cultivation systems treated with HKE physical resonance titanium plates maintained stable and sufficient dissolved oxygen levels, thereby suppressing environments favorable to anaerobic bacteria.
In contrast, conventional cultivation conditions with insufficient dissolved oxygen promoted anaerobic bacterial growth, resulting in extensive white spot formation on the culture surface.
The results show that cultivation systems treated with HKE physical resonance titanium plates maintained stable and sufficient dissolved oxygen levels, thereby suppressing environments favorable to anaerobic bacteria.
In contrast, conventional cultivation conditions with insufficient dissolved oxygen promoted anaerobic bacterial growth, resulting in extensive white spot formation on the culture surface.
Conventional mineral resonance materials or far-infrared radiation exhibit limited effectiveness in altering seawater structure, largely due to interference from high mineral and sodium chloride concentrations. The HKE physical resonance technology applied in this study is a purely physical approach and provides stable dissolved oxygen benefits in both freshwater and seawater environments, thereby improving microbial ecology.
A2|Marine Haematococcus pluvialis RAS: Increased DO and Restoration of Healthy Seawater pH
 In this experiment, the marine strain of Haematococcus pluvialis was cultivated in three RAS seawater tanks for a period of three weeks.
Titanium-based HKE physical resonance plates were installed in one tank group to evaluate their effects on dissolved oxygen (DO) and pH levels.
In this experiment, the marine strain of Haematococcus pluvialis was cultivated in three RAS seawater tanks for a period of three weeks.
Titanium-based HKE physical resonance plates were installed in one tank group to evaluate their effects on dissolved oxygen (DO) and pH levels.
1. Dissolved Oxygen (DO) Data
 2. pH Values
2. pH Values

The results indicate that introducing HKE physical resonance technology (titanium plates) into RAS systems results in more stable water conditions, with DO and pH values approaching optimal ranges. Elevated and stable dissolved oxygen enhances photosynthetic efficiency while reducing anaerobic bacterial risk, whereas maintaining pH within a healthy seawater range improves system resilience and algal growth conditions.
HKE physical resonance is a purely physical water-structure optimization technology that does not alter water chemistry. Its mechanism simultaneously stabilizes dissolved oxygen, optimizes pH balance, suppresses anaerobic bacteria, and comprehensively enhances RAS water quality.
A3|Comparison of Haematococcus pluvialis Cell Density (NKUST-1 vs. NKUST-1 + Ti)
To further verify biomass-level effects, cell density was used as a quantitative indicator to compare growth between untreated cultures (NKUST-1) and those treated with HKE resonance titanium systems (NKUST-1 + Ti). Under identical cultivation conditions, the treated group exhibited a statistically significant increase in cell density (p < 0.01), indicating that water condition optimization translates directly into enhanced algal growth performance.

B. Carbon Dioxide Uptake Capacity of Spirulina (CO₂ Uptake Capacity)
 This experiment focused on Spirulina platensis and evaluated its carbon dioxide (CO₂) uptake capacity
during cultivation as an important indicator of photosynthetic efficiency and metabolic activity.
Carbon fixation efficiency reflects not only the real-time photosynthetic status of algal cells, but also
its potential impact on subsequent biomass accumulation and the production of functional bioactive compounds.
This experiment focused on Spirulina platensis and evaluated its carbon dioxide (CO₂) uptake capacity
during cultivation as an important indicator of photosynthetic efficiency and metabolic activity.
Carbon fixation efficiency reflects not only the real-time photosynthetic status of algal cells, but also
its potential impact on subsequent biomass accumulation and the production of functional bioactive compounds.
Based on the experimental results, under identical cultivation conditions:
C. C-Phycocyanin (C-PC) Extraction Efficiency and Antioxidant Activity
The CO₂ uptake capacity test indicates that introducing physical water-conditioning during the cultivation stage significantly enhances photosynthetic efficiency and overall metabolic activity in Spirulina. This improved metabolic foundation is expected to further influence the generation and extractability of downstream functional compounds.
Based on the above results, this study further conducted quantitative extraction and antioxidant activity analysis of C-phycocyanin (C-PC), one of the most representative functional proteins in Spirulina.
C1|C-PC Purity and Concentration
Spirulina was cultivated under freshwater conditions. Throughout the experiment, a microalgae cultivation system established by Dr. Feng-Chieh Su (Department of Marine Biotechnology, National Kaohsiung University of Science and Technology) was applied to maintain microbial balance and ensure stable algal growth.
The analytical results demonstrate that water treatment conditions have a significant impact on C-PC extraction efficiency.

• Sample A (Control)
C-PC purity: 1.378
C-PC concentration: 0.070 mg/mL
→ Classified as crude extraction grade

• Sample B (Experimental)
C-PC purity: 2.619
C-PC concentration: 0.324 mg/mL
→ Both purity and concentration were significantly improved
Compared with the control group, the experimental group exhibited an approximately 4.6-fold increase in C-PC concentration. Purity increased from crude extraction level to a range considered suitable for food-grade and functional applications (purity > 1.5). This result indicates that physical water resonance treatment—by enhancing metabolic efficiency and stabilizing cultivation conditions—significantly increases the proportion of extractable bioactive C-PC molecules.
C2|Antioxidant Activity Evaluation (DPPH Radical Scavenging Assay)
 The antioxidant activity of extracted C-PC was further evaluated using the DPPH free radical scavenging assay:
The antioxidant activity of extracted C-PC was further evaluated using the DPPH free radical scavenging assay:
# Portions of this page are based on experimental observations and cultivation systems developed by Professor Su’s research team, Department of Marine Biotechnology.
 Spirulina (Spirulina) and Haematococcus pluvialis are high-value microalgae associated with two representative bioactive components—C-phycocyanin (C-PC) and astaxanthin, respectively.
In large-scale production, instability in cultivation water conditions—such as insufficient dissolved oxygen (DO), DO fluctuations, or pH deviation—often adversely affects algal growth, microbial ecology, and extraction efficiency.
Spirulina (Spirulina) and Haematococcus pluvialis are high-value microalgae associated with two representative bioactive components—C-phycocyanin (C-PC) and astaxanthin, respectively.
In large-scale production, instability in cultivation water conditions—such as insufficient dissolved oxygen (DO), DO fluctuations, or pH deviation—often adversely affects algal growth, microbial ecology, and extraction efficiency.Experimental studies and observations conducted with the participation of Professor Su’s research team from the Department of Marine Biotechnology, National Kaohsiung University of Science and Technology, demonstrate the application value of HKE physical resonance technology – based water regulation in microalgae cultivation and extraction processes.
Overview of Research Methods
This integrated study covers three main aspects:
-
Haematococcus pluvialis (freshwater) cultivation: Plate cultivation was used to compare differences in bacterial proliferation with and without HKE resonance titanium plate treatment.
Experimental results of freshwater Haematococcus pluvialis cultivation tanks. -
Haematococcus pluvialis (marine strain) cultivation in an RAS (Recirculating Aquaculture System): Three seawater RAS tanks were operated in parallel, with titanium-based HKE hydrogen kinetic resonance plates installed in one group, comparing DO and pH after three weeks.
Water quality test results of marine Haematococcus pluvialis RAS cultivation tanks. -
C-phycocyanin (C-PC) extraction from Spirulina: Under identical algal species and probiotic cultivation conditions, C-PC purity, concentration, and DPPH antioxidant performance were compared between the control group and the group treated with HKE resonance technology applied during both cultivation and extraction stages.
Comparison of C-PC extraction conditions and the impact of HKE physical resonance technology.
A. Cultivation Results: Water Quality Advantages Derived from DO and pH Stability
A1|Freshwater Haematococcus pluvialis: Plate Cultivation Reveals Differences in Microbial Profiles
The results show that cultivation systems treated with HKE physical resonance titanium plates maintained stable and sufficient dissolved oxygen levels, thereby suppressing environments favorable to anaerobic bacteria.
In contrast, conventional cultivation conditions with insufficient dissolved oxygen promoted anaerobic bacterial growth, resulting in extensive white spot formation on the culture surface.
The results show that cultivation systems treated with HKE physical resonance titanium plates maintained stable and sufficient dissolved oxygen levels, thereby suppressing environments favorable to anaerobic bacteria.
In contrast, conventional cultivation conditions with insufficient dissolved oxygen promoted anaerobic bacterial growth, resulting in extensive white spot formation on the culture surface.Conventional mineral resonance materials or far-infrared radiation exhibit limited effectiveness in altering seawater structure, largely due to interference from high mineral and sodium chloride concentrations. The HKE physical resonance technology applied in this study is a purely physical approach and provides stable dissolved oxygen benefits in both freshwater and seawater environments, thereby improving microbial ecology.
A2|Marine Haematococcus pluvialis RAS: Increased DO and Restoration of Healthy Seawater pH
 In this experiment, the marine strain of Haematococcus pluvialis was cultivated in three RAS seawater tanks for a period of three weeks.
Titanium-based HKE physical resonance plates were installed in one tank group to evaluate their effects on dissolved oxygen (DO) and pH levels.
In this experiment, the marine strain of Haematococcus pluvialis was cultivated in three RAS seawater tanks for a period of three weeks.
Titanium-based HKE physical resonance plates were installed in one tank group to evaluate their effects on dissolved oxygen (DO) and pH levels.1. Dissolved Oxygen (DO) Data
| Tank Group | Setup | DO (ppm) |
| Control A1 | No Ti plates | 5.8 |
| Control B1 | No Ti plates | 6.0 |
| Ti System | With Ti plates | 7.8 |

| Tank Group | Setup | pH |
| Control A1 | No Ti plates | 5.7 |
| Control B1 | No Ti plates | 6.0 |
| Ti System | With Ti plates | 8.0 |

The results indicate that introducing HKE physical resonance technology (titanium plates) into RAS systems results in more stable water conditions, with DO and pH values approaching optimal ranges. Elevated and stable dissolved oxygen enhances photosynthetic efficiency while reducing anaerobic bacterial risk, whereas maintaining pH within a healthy seawater range improves system resilience and algal growth conditions.
HKE physical resonance is a purely physical water-structure optimization technology that does not alter water chemistry. Its mechanism simultaneously stabilizes dissolved oxygen, optimizes pH balance, suppresses anaerobic bacteria, and comprehensively enhances RAS water quality.
A3|Comparison of Haematococcus pluvialis Cell Density (NKUST-1 vs. NKUST-1 + Ti)
To further verify biomass-level effects, cell density was used as a quantitative indicator to compare growth between untreated cultures (NKUST-1) and those treated with HKE resonance titanium systems (NKUST-1 + Ti). Under identical cultivation conditions, the treated group exhibited a statistically significant increase in cell density (p < 0.01), indicating that water condition optimization translates directly into enhanced algal growth performance.

- NKUST-1 (control): ~ 70 ×104 cells/mL
- NKUST-1 + Ti (HKE-treated): ~ 120 ×104 cells/mL
- Approximately 70% increase in cell density
B. Carbon Dioxide Uptake Capacity of Spirulina (CO₂ Uptake Capacity)
 This experiment focused on Spirulina platensis and evaluated its carbon dioxide (CO₂) uptake capacity
during cultivation as an important indicator of photosynthetic efficiency and metabolic activity.
Carbon fixation efficiency reflects not only the real-time photosynthetic status of algal cells, but also
its potential impact on subsequent biomass accumulation and the production of functional bioactive compounds.
This experiment focused on Spirulina platensis and evaluated its carbon dioxide (CO₂) uptake capacity
during cultivation as an important indicator of photosynthetic efficiency and metabolic activity.
Carbon fixation efficiency reflects not only the real-time photosynthetic status of algal cells, but also
its potential impact on subsequent biomass accumulation and the production of functional bioactive compounds.
Based on the experimental results, under identical cultivation conditions:
- Spirulina cultures treated with the HKE physical resonance stick exhibited a significantly higher CO₂ uptake rate compared with conventionally cultivated controls.
- Relative to the control group, the treated group absorbed approximately 740 mg additional CO₂ per hour.
- These results indicate enhanced photosynthetic activity and carbon fixation efficiency under resonance-treated conditions.
C. C-Phycocyanin (C-PC) Extraction Efficiency and Antioxidant Activity
The CO₂ uptake capacity test indicates that introducing physical water-conditioning during the cultivation stage significantly enhances photosynthetic efficiency and overall metabolic activity in Spirulina. This improved metabolic foundation is expected to further influence the generation and extractability of downstream functional compounds.
Based on the above results, this study further conducted quantitative extraction and antioxidant activity analysis of C-phycocyanin (C-PC), one of the most representative functional proteins in Spirulina.
C1|C-PC Purity and Concentration
Spirulina was cultivated under freshwater conditions. Throughout the experiment, a microalgae cultivation system established by Dr. Feng-Chieh Su (Department of Marine Biotechnology, National Kaohsiung University of Science and Technology) was applied to maintain microbial balance and ensure stable algal growth.
-
Sample A (Control Group)
Spirulina was cultivated in freshwater supplemented with probiotics. After cultivation, C-PC extraction was conducted without additional water treatment. -
Sample B (Experimental Group)
Under identical freshwater and probiotic cultivation conditions, HKE physical resonance technology was continuously applied to the cultivation water. This physical resonance treatment stabilized dissolved oxygen and modified water molecular clustering, resulting in smaller and more uniform molecular structures. During the C-PC extraction process, HKE resonance treatment was also continuously applied to ensure consistency throughout all stages.
The analytical results demonstrate that water treatment conditions have a significant impact on C-PC extraction efficiency.

• Sample A (Control)
C-PC purity: 1.378
C-PC concentration: 0.070 mg/mL
→ Classified as crude extraction grade

• Sample B (Experimental)
C-PC purity: 2.619
C-PC concentration: 0.324 mg/mL
→ Both purity and concentration were significantly improved
Compared with the control group, the experimental group exhibited an approximately 4.6-fold increase in C-PC concentration. Purity increased from crude extraction level to a range considered suitable for food-grade and functional applications (purity > 1.5). This result indicates that physical water resonance treatment—by enhancing metabolic efficiency and stabilizing cultivation conditions—significantly increases the proportion of extractable bioactive C-PC molecules.
C2|Antioxidant Activity Evaluation (DPPH Radical Scavenging Assay)
 The antioxidant activity of extracted C-PC was further evaluated using the DPPH free radical scavenging assay:
The antioxidant activity of extracted C-PC was further evaluated using the DPPH free radical scavenging assay:
- Sample A (method A) exhibited a radical scavenging rate of approximately 55–60%.
- Sample B (method B) showed an increased scavenging rate of approximately 65%.
- Both samples were significantly higher than the control group, exceeding it by 40–50% (control: approximately 15%)
# Portions of this page are based on experimental observations and cultivation systems developed by Professor Su’s research team, Department of Marine Biotechnology.

